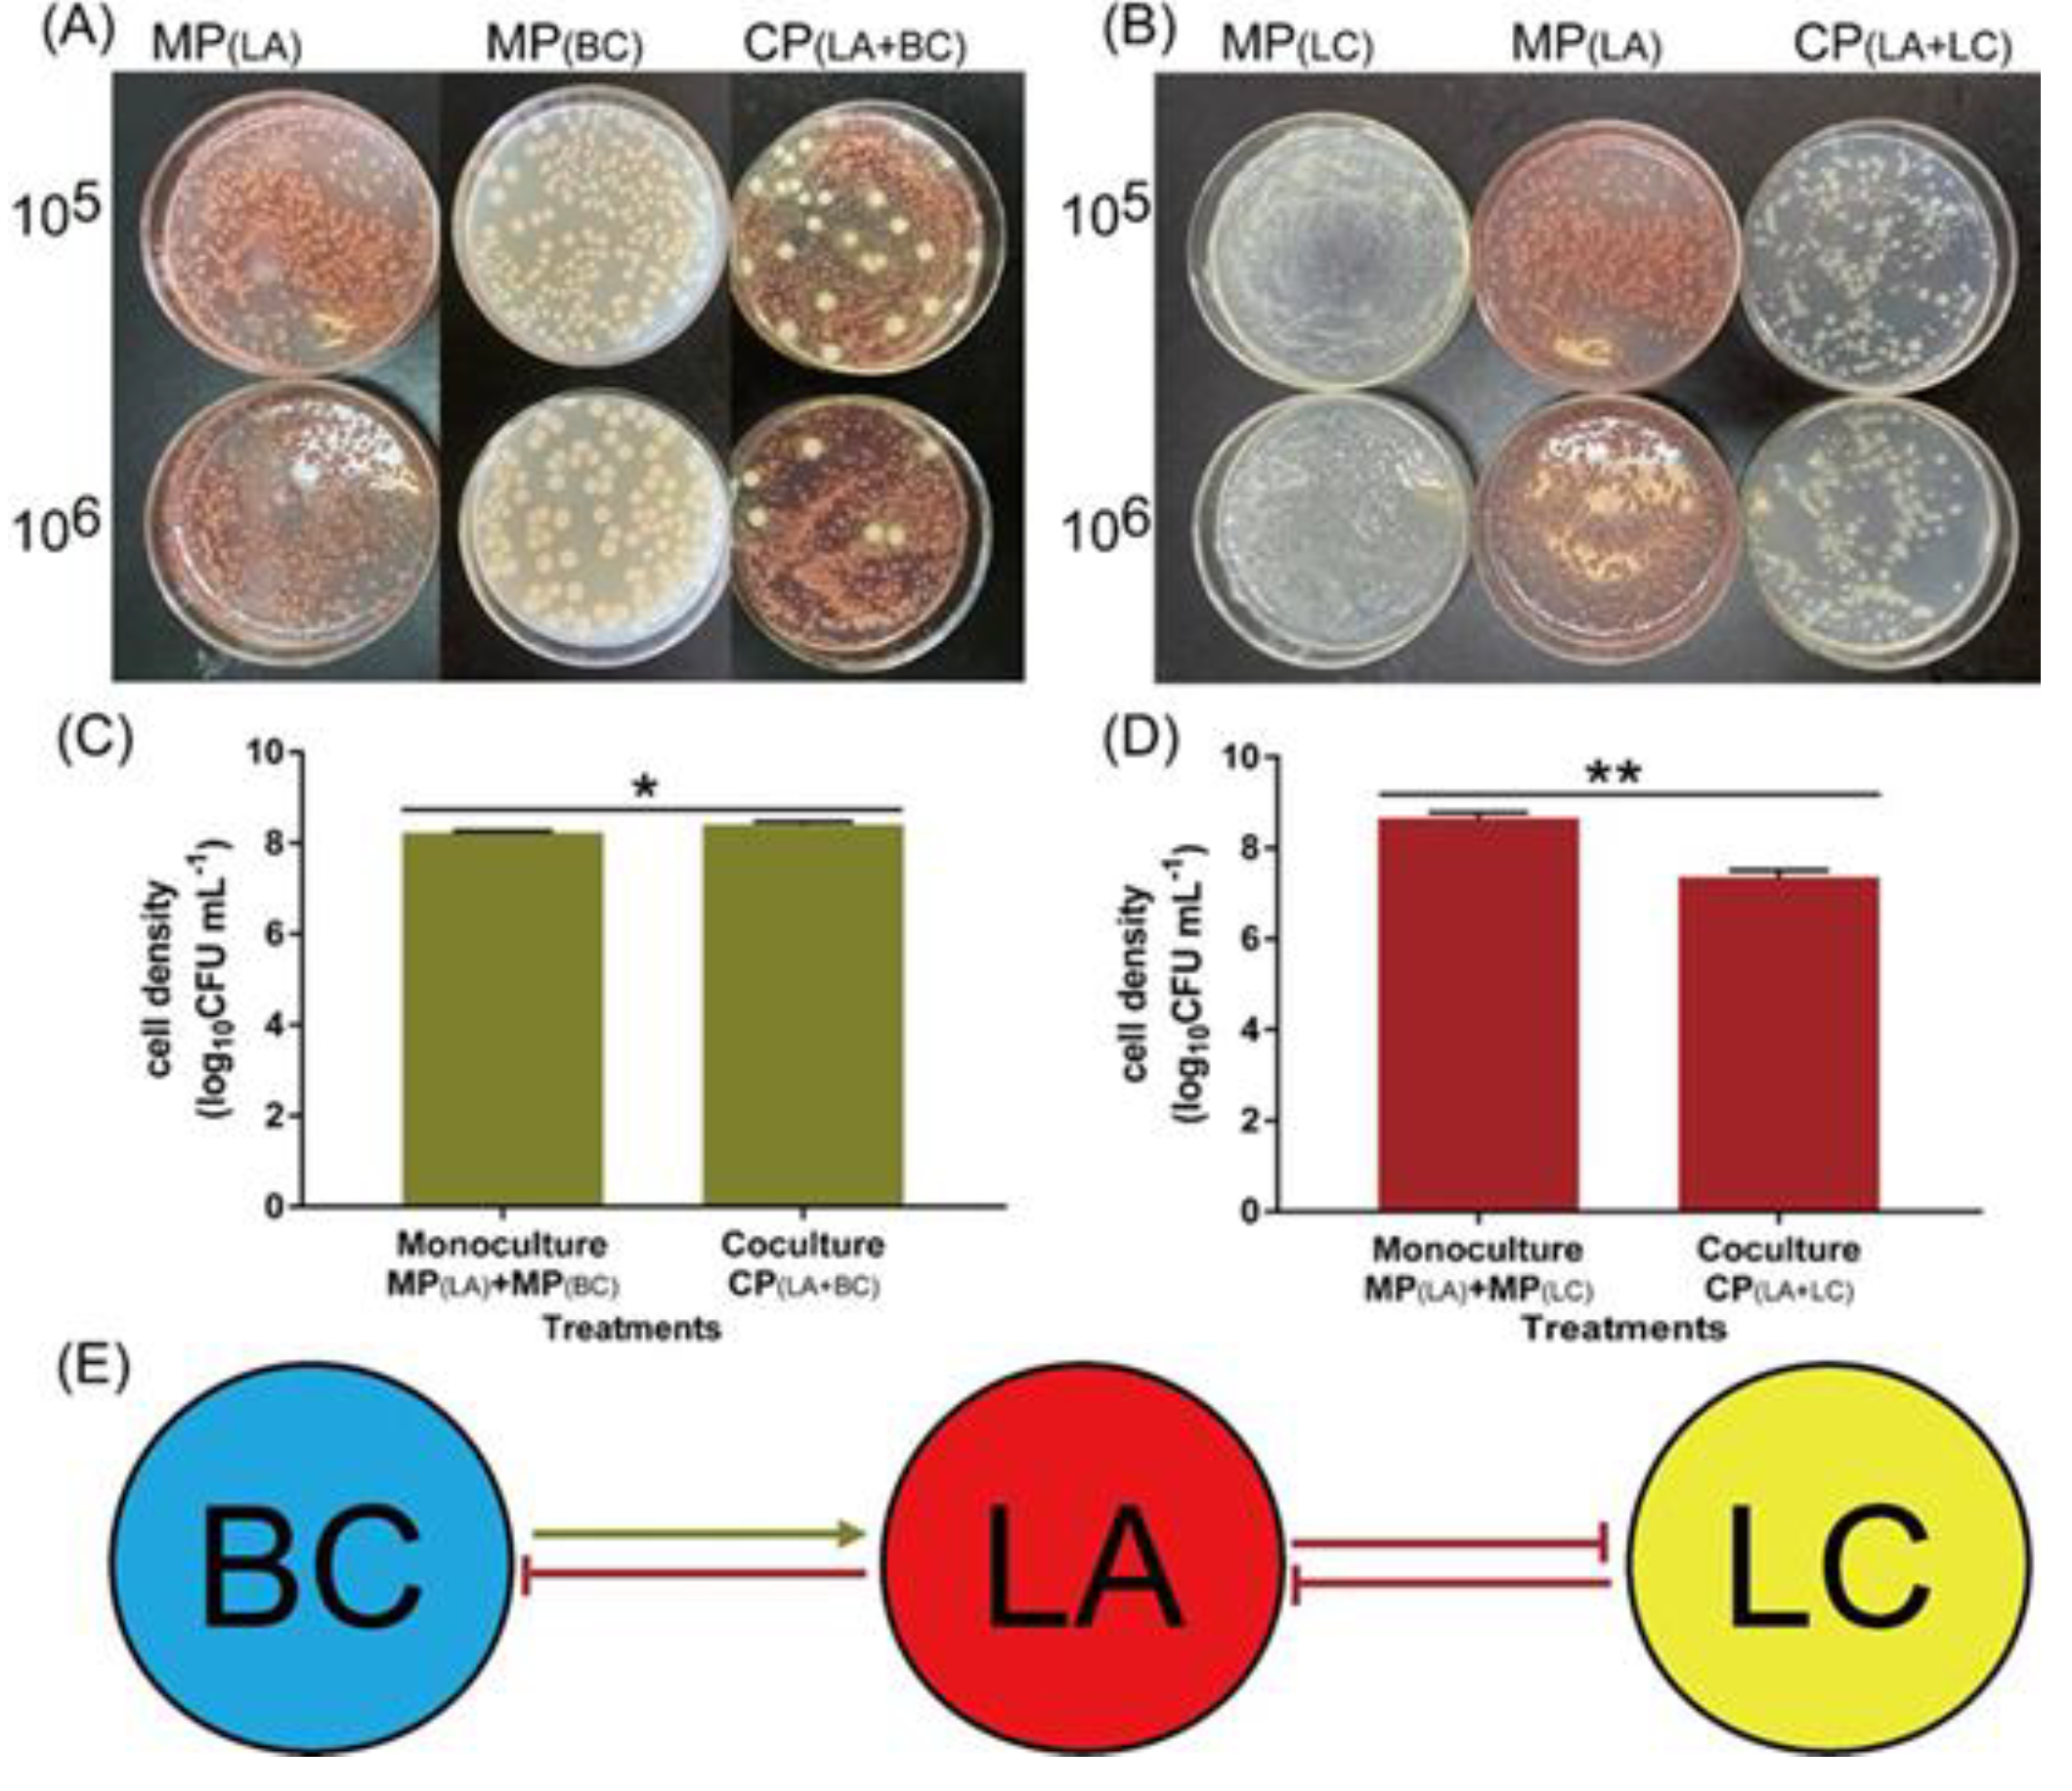
Agronomy 11 02424 g001 Agronomy 11 02424 g001

Unraveling the Association between Metabolic Changes in Inter-Genus and Intra-Genus Bacteria to Mitigate Clubroot Disease of Chinese Cabbage
Abstract
1. Introduction
2. Materials and Methods
2.1. Experimental Site Description
2.2. Preparation of Pathogen Spore Suspension
2.3. Bacterial Strains, Growth Medium, Culture Conditions, and Assembly of Bacterial Co-Culture and Mono-Culture
2.4. In-Vivo Assay
2.4.1. Raising of Nursery
2.4.2. Greenhouse Experiment
2.4.3. Evaluation of Plant Growth Promotion, Disease Index, and Biocontrol Efficacy
2.5. Investigation of Pairwise Interactions between Biocontrol Strains
2.6. Growth Kinetics of Candidate Bacterial Strains in Co–Culture Assay
2.7. Metabolomics Analysis
2.7.1. Metabolites Extraction
2.7.2. LC-MS Analysis
2.7.3. Data Processing
2.8. Identification of Differential Metabolites
2.9. Pathway Enrichment Analysis
2.10. Statistical Analysis
3. Results
3.1. Effect of Microbial Co-Culture and Mono-Culture on Plant Growth and Incidence of Clubroot Disease
3.2. Determining Pairwise Interactions between Bacterial Co-Culture
3.3. Growth Rates of Mono-Culture and Co-Culture Biocontrol Agents
3.4. Metabolomics Outline for Microbial Biocontrol Agents
3.5. Multivariate Analysis for Differentially Expressed Metabolites
3.6. KEGG Enrichment Pathways for Differentially Expressed Metabolites
3.7. Interaction Network of Mono-Culture and Co-Culture Biocontrol Agents in Primary Metabolism Pathway
3.8. Differentially Expressed Metabolites Related to Plant Growth and Antimicrobial Function
4. Discussion
5. Conclusions
Supplementary Materials
Author Contributions
Funding
Data Availability Statement
Conflicts of Interest
References
- Liu, C.; Yang, Z.; He, P.; Munir, S.; He, P.; Wu, Y.; Ho, H.; He, Y. Fluazinam positively affected the microbial communities in clubroot cabbage rhizosphere. Sci. Hortic. 2019, 256, 108519. [Google Scholar] [CrossRef]
- Wang, Y.; Luo, W.; Huang, Y.; Xu, L.; Yin, Y. Improved control of clubroot (Plasmodiophora brassicae) by a mixture of a fungicide and a plant defense inducer. J. Plant Dis. Prot. 2017, 124, 67. [Google Scholar] [CrossRef]
- Chai, A.L.; Xie, X.W.; Shi, Y.X.; Li, B.J. Research status of clubroot (Plasmodiophora brassicae) on cruciferous crops in China. Can. J. Plant Pathol. 2014, 36, 142. [Google Scholar] [CrossRef]
- Niemann, J.; Kaczmarek, J.; Książczyk, T.; Wojciechowski, A.; Jedryczka, M. Chinese cabbage (Brassica rapa ssp. pekinensis)–A valuable source of resistance to clubroot (Plasmodiophora brassicae). Eur. J. Plant Pathol. 2017, 147, 181. [Google Scholar] [CrossRef]
- Zahr, K.; Sarkes, A.; Yang, Y.; Ahmed, H.; Zhou, Q.; Feindel, D.; Harding, M.W.; Feng, J. Plasmodiophora brassicae in Its Environment-: Effects of Temperature and Light on Resting Spore Survival in Soil. Phytopathology 2021, 9, 819524. [Google Scholar] [CrossRef] [PubMed]
- Peng, L.; Zhou, L.; Li, Q.; Wei, D.; Ren, X.; Song, H.; Mei, J.; Si, J.; Qian, W. Identification of Quantitative Trait Loci for Clubroot Resistance in Brassica oleracea With the Use of Brassica SNP Microarray. Front. Plant Sci. 2018, 9, 822. [Google Scholar] [CrossRef] [PubMed]
- Shah, N.; Sun, J.; Yu, S.; Yang, Z.; Wang, Z.; Huang, F.; Dun, B.; Gong, J.; Liu, Y.; Li, Y.; et al. Genetic variation analysis of field isolates of clubroot and their responses to Brassica napus lines containing resistant genes CRb and PbBa8. 1 and their combination in homozygous and heterozygous state. Mol. Breed. 2019, 39, 1–1153. [Google Scholar] [CrossRef]
- Zhu, M.; He, Y.; Li, Y.; Ren, T.; Liu, H.; Huang, J.; Jiang, D.; Hsiang, T.; Zheng, L. Two New Biocontrol Agents Against Clubroot Caused by Plasmodiophora brassicae. Front. Microbiol. 2020, 10, 3099. [Google Scholar] [CrossRef] [PubMed]
- Zhou, L.; Zhang, L.; He, Y.; Liu, F.; Li, M.; Wang, Z.; Ji, G. Isolation and characterization of bacterial isolates for biological control of clubroot on Chinese cabbage. Eur. J. Plant Pathol. 2014, 140, 159. [Google Scholar] [CrossRef][Green Version]
- Laborda, P.; Zhao, Y.; Ling, J.; Hou, R.; Liu, F. Production of Antifungal p-Aminobenzoic Acid in Lysobacter antibioticus OH13. J. Agric. Food Chem. 2018, 66, 630. [Google Scholar] [CrossRef]
- Palmieri, D.; Vitullo, D.; De Curtis, F.; Lima, G. A microbial consortium in the rhizosphere as a new biocontrol approach against fusarium decline of chickpea. Plant Soil 2017, 412, 425. [Google Scholar] [CrossRef]
- Goh, Y.K.; Marzuki, N.F.; Tuan Pa, T.N.F.T.; Goh, T.-K.; Kee, Z.S.; Goh, Y.K.; Yusof, M.T.; Vujanovic, V.; Goh, K.J. Biocontrol and Plant-Growth-Promoting Traits of Talaromyces apiculatus and Clonostachys rosea Consortium against Ganoderma Basal Stem Rot Disease of Oil Palm. Microorganisms 2020, 8, 1138. [Google Scholar] [CrossRef]
- Cai, Q.; Zhou, G.; Ahmed, W.; Cao, Y.; Zhao, M.; Li, Z.; Zhao, Z. Study on the relationship between bacterial wilt and rhizo-spheric microbial diversity of flue-cured tobacco cultivars. Eur. J. Plant Pathol. 2021, 160, 265–276. [Google Scholar] [CrossRef]
- Li, C.; Ahmed, W.; Li, D.; Yu, L.; Xu, L.; Xu, T.; Zhao, Z. Biochar suppresses bacterial wilt disease of flue-cured tobacco by improving soil health and functional diversity of rhizosphere microorganisms. Appl. Soil Ecol. 2021, 171, p104314. [Google Scholar] [CrossRef]
- Fu, L.; Li, H.; Wei, L.; Yang, J.; Liu, Q.; Wang, Y.; Wang, X.; Ji, G. Antifungal and Biocontrol Evaluation of Four Lysobacter Strains Against Clubroot Disease. Indian J. Microbiol. 2018, 58, 353. [Google Scholar] [CrossRef]
- Zhang, J.; Wei, L.; Yang, J.; Ahmed, W.; Wang, Y.; Fu, L.; Ji, G. Probiotic Consortia: Reshaping the Rhizospheric Microbiome and Its Role in Suppressing Root-Rot Disease of Panax notoginseng. Front. Microbiol. 2020, 11, 701. [Google Scholar] [CrossRef]
- Ma, Q.; Bi, Y.-H.; Wang, E.-X.; Zhai, B.-B.; Dong, X.-T.; Qiao, B.; Ding, M.-Z.; Yuan, Y.-J. Integrated proteomic and metabolomic analysis of a reconstructed three-species microbial consortium for one-step fermentation of 2-keto-l-gulonic acid, the precursor of vitamin C. J. Ind. Microbiol. Biotechnol. 2019, 46, 21. [Google Scholar] [CrossRef]
- Yao, Z.; Guo, Z.; Wang, Y.; Li, W.; Fu, Y.; Lin, Y.; Lin, W.; Lin, X. Integrated Succinylome and Metabolome Profiling Reveals Crucial Role of S-Ribosylhomocysteine Lyase in Quorum Sensing and Metabolism of Aeromonas hydrophila*. Mol. Cell. Proteom. 2019, 18, 200. [Google Scholar] [CrossRef] [PubMed]
- Paul, C.; Mausz, M.A.; Pohnert, G. A co-culturing/metabolomics approach to investigate chemically mediated interactions of planktonic organisms reveals influence of bacteria on diatom metabolism. Metabolomics 2013, 9, 349. [Google Scholar] [CrossRef]
- Li, J.; Zhao, X.; Nishimura, Y.; Fukumoto, Y. Correlation between Bolting and Physiological Properties in Chinese Cabbage (Brassica rapa L. pekinensis Group). J. Jpn. Soc. Hortic. Sci. 2010, 79, 294. [Google Scholar] [CrossRef]
- Liu, C.; Yang, Z.; He, P.; Munir, S.; Wu, Y.; Ho, H.; He, Y. Deciphering the bacterial and fungal communities in clubroot-affected cabbage rhizosphere treated with Bacillus Subtilis XF-1. Agric. Ecosyst. Environ. 2018, 256, 12. [Google Scholar] [CrossRef]
- Lopatkin, A.J.; Stokes, J.M.; Zheng, E.J.; Yang, J.H.; Takahashi, M.K.; You, L.; Collins, J.J. Bacterial metabolic state more ac-curately predicts antibiotic lethality than growth rate. Nat. Microbiol. 2019, 4, 2109. [Google Scholar] [CrossRef] [PubMed]
- Zhai, Q.; Xiao, Y.; Narbad, A.; Chen, W. Comparative metabolomic analysis reveals global cadmium stress response of Lacto-bacillus plantarum strains. Metallomics 2018, 10, 1065. [Google Scholar] [CrossRef] [PubMed]
- Van den Eede, N.V.D.; Cuykx, M.; Rodrigues, R.M.; Laukens, K.; Neels, H.; Covaci, A.; Vanhaecke, T. Metabolomics analysis of the toxicity pathways of triphenyl phosphate in HepaRG cells and comparison to oxidative stress mechanisms caused by aceta-minophen. Toxicol. Vitr. 2015, 29, 2045. [Google Scholar] [CrossRef] [PubMed]
- Cui, H.; Li, Y.; Cao, M.; Liao, J.; Liu, X.; Miao, J.; Fu, H.; Song, R.; Wen, W.; Zhang, Z.; et al. Untargeted Metabolomic Analysis of the Effects and Mechanism of Nuciferine Treatment on Rats With Nonalcoholic Fatty Liver Disease. Front. Pharmacol. 2020, 11, 858. [Google Scholar] [CrossRef]
- Booth, S.C.; Weljie, A.M.; Turner, R.J. Metabolomics reveals differences of metal toxicity in cultures of Pseudomonas pseudoal-caligenes KF707 grown on different carbon sources. Front. Microbiol. 2015, 6, 827. [Google Scholar] [CrossRef] [PubMed]
- Wan, X.; Yang, J.; Ahmed, W.; Liu, Q.; Wang, Y.; Wei, L.; Ji, G. Functional analysis of pde gene and its role in the pathogenesis of Xanthomonas oryzae pv. oryzicola. Infect. Genet. Evol. 2021, 94, p105008. [Google Scholar] [CrossRef]
- Ahmed, A.; Munir, S.; He, P.; Li, Y.; He, P.; Yixin, W.; He, Y. Biocontrol arsenals of bacterial endophyte: An imminent triumph against clubroot disease. Microbiol. Res. 2020, 241, 126565. [Google Scholar] [CrossRef]
- Sarma, B.K.; Yadav, S.K.; Singh, S.; Singh, H.B. Microbial consortium-mediated plant defense against phytopathogens: Read-dressing for enhancing efficacy. Soil Biol. Biochem. 2015, 87, 25. [Google Scholar] [CrossRef]
- Park, S.; Seo, Y.-S.; Hegeman, A.D. Plant metabolomics for plant chemical responses to belowground community change by climate change. J. Plant Biol. 2014, 57, 137. [Google Scholar] [CrossRef]
- Munir, S.; Li, Y.; He, P.; He, P.; Ahmed, A.; Wu, Y.; He, Y. Unraveling the metabolite signature of citrus showing defense re-sponse towards Candidatus Liberibacter asiaticus after application of endophyte Bacillus subtilis L1-21. Microbiol. Res. 2020, 234, 126425. [Google Scholar] [CrossRef]
- Schelli, K.; Zhong, F.; Zhu, J. Comparative metabolomics revealing Staphylococcus aureus metabolic response to different antibiotics. Microb. Biotechnol. 2017, 10, 1764. [Google Scholar] [CrossRef] [PubMed]
- Moye, Z.D.; Zeng, L.; Burne, R.A. Fueling the caries process: Carbohydrate metabolism and gene regulation by Streptococcus mutans. J. Oral Microbiol. 2014, 6, 24878. [Google Scholar] [CrossRef]
- Peng, B.; Su, Y.-B.; Li, H.; Han, Y.; Guo, C.; Tian, Y.-M.; Peng, X.-X. Exogenous Alanine and/or Glucose plus Kanamycin Kills Antibiotic-Resistant Bacteria. Cell Metab. 2015, 21, 249. [Google Scholar] [CrossRef]
- Ren, W.X.; Han, J.; Uhm, S.; Jang, Y.J.; Kang, C.; Kim, J.-H.; Kim, J.S. Recent development of biotin conjugation in biological imaging, sensing, and target delivery. Chem. Commun. 2015, 51, 10403–10418. [Google Scholar] [CrossRef]
- Zhang, A.; Ackley, B.D.; Yan, D. Vitamin B12 Regulates Glial Migration and Synapse Formation through Isoform-Specific Control of PTP-3/LAR PRTP Expression. Cell Rep. 2020, 30, 3981. [Google Scholar] [CrossRef] [PubMed]
- Haruta, S.; Kato, S.; Yamamoto, K.; Igarashi, Y. Intertwined interspecies relationships: Approaches to untangle the microbial network. Environ. Microbiol. 2009, 11, 2963. [Google Scholar] [CrossRef]
- Embree, M.; Liu, J.K.; Al-Bassam, M.M.; Zengler, K. Networks of energetic and metabolic interactions define dynamics in microbial communities. Proc. Natl. Acad. Sci. USA 2015, 112, 15450. [Google Scholar] [CrossRef]
- Du, J.; Zhou, J.; Xue, J.; Song, H.; Yuan, Y. Metabolomic profiling elucidates community dynamics of the Ketogulonicigenium vulgare–Bacillus megaterium consortium. Metabolomics 2012, 8, 960. [Google Scholar] [CrossRef]
- Westhoff, S.; van Wezel, G.P.; E Rozen, D.E. Distance-dependent danger responses in bacteria. Curr. Opin. Microbiol. 2017, 36, 95. [Google Scholar] [CrossRef]
- Mishra, J.; Arora, N.K. Secondary metabolites of fluorescent pseudomonads in biocontrol of phytopathogens for sustainable agriculture. Appl. Soil Ecol. 2018, 125, 35. [Google Scholar] [CrossRef]
- Schulz-Bohm, K.; Zweers, H.; de Boer, W.; Garbeva, P. A fragrant neighborhood: Volatile mediated bacterial interactions in soil. Front. Microbiol. 2015, 6, 1212. [Google Scholar] [CrossRef]
- Myo, E.M.; Liu, B.; Ma, J.; Shi, L.; Jiang, M.; Zhang, K.; Ge, B. Evaluation of Bacillus velezensis NKG-2 for bio-control activities against fungal diseases and potential plant growth promotion. Biol. Control 2019, 134, 23. [Google Scholar] [CrossRef]
- Xu, L.; Ren, L.; Chen, K.; Liu, F.; Fang, X. Putative role of IAA during the early response of Brassica napus L. to Plasmodiophora brassicae. Eur. J. Plant Pathol. 2016, 145, 601–613. [Google Scholar] [CrossRef]
- Lemarié, S.; Robert-Seilaniantz, A.; Lariagon, C.; Lemoine, J.; Marnet, N.; Jubault, M.; Manzanares-Dauleux, M.J.; Gravot, A. Both the Jasmonic Acid and the Salicylic Acid Pathways Contribute to Resistance to the Biotrophic Clubroot Agent Plasmodiophora brassicae in Arabidopsis. Plant Cell Physiol. 2015, 56, 2158–2168. [Google Scholar] [CrossRef] [PubMed]
- Zhao, Y.; Qian, G.; Ye, Y.; Wright, S.; Chen, H.; Shen, Y.; Liu, F.; Du, L. Heterocyclic Aromatic N-Oxidation in the Biosynthesis of Phenazine Antibiotics from Lysobacter antibioticus. Org. Lett. 2016, 18, 2495–2498. [Google Scholar] [CrossRef]
- Nawaz, N.U.A.; Saeed, M.; Khan, K.M.; Ali, I.; Bhatti, H.A.; Sabi-Ur-Rehman; Shahid, M.; Faizi, S. Isolation of tyrosine derived phenolics and their possible beneficial role in anti-inflammatory and antioxidant potential of Tithonia tubaeformis. Nat. Prod. Res. 2020, 19, 1–9. [Google Scholar] [CrossRef]

| Treatment | Disease Index (%) | Control Effect (%) | Average Fresh Weight (g)/Plant |
|---|---|---|---|
| L. antibioticus 13-6 | 42.22 ± 2.11bc | 42.73 ± 1.63b | 104.65 ± 2.52c |
| L. capsici ZST1-2 | 39.40 ± 4.55bc | 46.56 ± 2.58b | 118.70 ± 3.03b |
| B. cereus BT-23 | 61.62 ± 6.51ab | 16.43 ± 2.93c | 102.40 ± 3.11c |
| L. antibioticus 13-6 + B. cereus BT-23 | 31.31 ± 5.65c | 57.53 ± 3.47a | 127.35 ± 7.46a |
| L. antibioticus 13-6 + L. capsici ZST1-2 | 46.67 ± 4.43bc | 36.71 ± 0.91b | 117.65 ± 2.07b |
| CK | 73.73 ± 4.12a | / | 52.10 ± 2.73d |
Publisher’s Note: MDPI stays neutral with regard to jurisdictional claims in published maps and institutional affiliations. |
© 2021 by the authors. Licensee MDPI, Basel, Switzerland. This article is an open access article distributed under the terms and conditions of the Creative Commons Attribution (CC BY) license (https://creativecommons.org/licenses/by/4.0/).
Share and Cite
Wei, L.; Yang, J.; Ahmed, W.; Xiong, X.; Liu, Q.; Huang, Q.; Ji, G. Unraveling the Association between Metabolic Changes in Inter-Genus and Intra-Genus Bacteria to Mitigate Clubroot Disease of Chinese Cabbage. Agronomy 2021, 11, 2424. https://doi.org/10.3390/agronomy11122424
Wei L, Yang J, Ahmed W, Xiong X, Liu Q, Huang Q, Ji G. Unraveling the Association between Metabolic Changes in Inter-Genus and Intra-Genus Bacteria to Mitigate Clubroot Disease of Chinese Cabbage. Agronomy. 2021; 11(12):2424. https://doi.org/10.3390/agronomy11122424
Chicago/Turabian StyleWei, Lanfang, Jun Yang, Waqar Ahmed, Xinying Xiong, Qi Liu, Qiong Huang, and Guanghai Ji. 2021. "Unraveling the Association between Metabolic Changes in Inter-Genus and Intra-Genus Bacteria to Mitigate Clubroot Disease of Chinese Cabbage" Agronomy 11, no. 12: 2424. https://doi.org/10.3390/agronomy11122424
APA StyleWei, L., Yang, J., Ahmed, W., Xiong, X., Liu, Q., Huang, Q., & Ji, G. (2021). Unraveling the Association between Metabolic Changes in Inter-Genus and Intra-Genus Bacteria to Mitigate Clubroot Disease of Chinese Cabbage. Agronomy, 11(12), 2424. https://doi.org/10.3390/agronomy11122424

